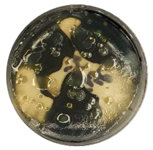
Coatings 15 01101 i002
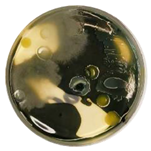
Coatings 15 01101 i004
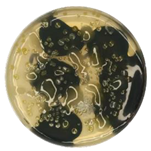
Coatings 15 01101 i011
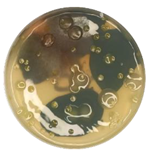
Coatings 15 01101 i012
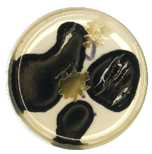
Coatings 15 01101 i016

1. Introduction
Asphalt pavement is a critical component of modern transportation infrastructure, significantly impacting economic and social development. With rapid growth in traffic volume and natural environmental erosion, asphalt pavements frequently face distresses such as aging, cracking, and disintegration. The causes of these distresses include not only design flaws, substandard construction quality, traffic loads, and environmental factors but also microbial erosion of asphalt [
1]. Studies indicate that specific microorganisms can utilize organic components in asphalt as a nutrient source, growing and proliferating on its surface. This alters the physical and chemical properties of asphalt, leading to changes in its service performance [
2]. Therefore, in-depth investigation into the impact patterns of microorganisms on asphalt performance is crucial for preventing pavement distresses and enhancing the service life of asphalt pavements.
Microorganisms represent the most abundant and diverse biological resource on Earth, holding significant application potential in road engineering materials. For asphalt-based materials, the effects of microbial action vary considerably depending on microbial species. On one hand, microorganisms consume light fractions in asphalt as nutrients. Their growth on the asphalt surface causes pitting and continuous proliferation, increasing the relative content of high molecular weight substances (e.g., asphaltenes) and accelerating asphalt aging [
3,
4]. On the other hand, specific microorganisms can metabolize high molecular weight components in asphalt (e.g., asphaltenes and resins). This degradation process releases low molecular weight hydrocarbons (including alkanes, naphthenes, and aromatics) and oxygen-containing organic compounds (e.g., phenols and carboxylic acids) [
5,
6,
7]. These metabolites effectively replenish the light distillates (saturates and aromatics) lost during asphalt aging, restoring dynamic equilibrium within the colloidal structure by rebalancing component proportions.
Current research on the direct interaction between microorganisms and road asphalt remains limited. Existing studies predominantly use standardized microbial populations, lacking systematic investigation of microorganisms in in-service asphalt pavements [
5,
6,
8,
9]. Furthermore, prior research has not comprehensively revealed the specific impact patterns of microbial action on the macroscopic properties of asphalt. In particular, changes in the rheological properties of asphalt before and after microbial action are rarely reported. Therefore, the mechanism by which microorganisms affect asphalt in field environments remains insufficiently understood, necessitating more detailed studies.
To address these gaps, this study aims to investigate microbial types in the service environment of asphalt pavements and their impact on asphalt rheological properties. First, microbial strains were extracted from in-service asphalt pavements and their species identified. Subsequently, penetration, softening point, ductility, temperature sweep (TS), multiple stress creep recovery (MSCR) test, linear amplitude sweep (LAS), and 4mm dynamic shear rheometer (DSR) tests were employed to systematically analyze the effects of different microbial activity periods (5, 10, and 15 days) on the conventional and rheological properties of base asphalt and styrene-butadiene-styrene (SBS)-modified asphalt. The results of this study provide new theoretical insights into the mechanism of microbial action on asphalt and offer practical guidance for developing prevention strategies, performance optimization, and durability enhancement of asphalt pavement materials.
2. Materials and Methods
2.1. Materials
2.1.1. Culture Medium
All culture media are used exclusively for microbial extraction, screening, and cultivation, and are not involved in subsequent experimental procedures. During microbial isolation and screening, optimized culture medium formulations were used to support the growth of target microorganisms and their asphalt-degrading functionality. Medium components were determined through preliminary experiments based on microbial metabolic characteristics and adaptability to asphalt degradation.
Table 1 shows the different types of culture media used in this study, including mineral salt medium, asphalt liquid medium, asphalt solid medium, and Luria–Bertani (LB) solid medium. Mineral salt medium provided inorganic salts and trace elements required for microbial growth, supporting their basic metabolism. Asphalt liquid medium served as an organic carbon source for asphalt-degrading microorganisms, crucial for screening functional strains. Asphalt solid medium, based on asphalt liquid medium with added agar, facilitated the cultivation of solid colonies for target strain screening and purification. Finally, LB solid medium provided rich nutrients to support rapid microbial proliferation and extraction. All media were sterilized at 121 °C and 103.4 kPa for 30 min before use to ensure sterility.
2.1.2. Sampling and Suspension Preparation of Asphalt-Degrading
The microbial strains used in this study were obtained through sampling, enrichment, and screening from the surface layer of in-service asphalt pavement. To ensure acquisition of asphalt-degrading microorganisms, sampling points were selected considering traffic volume, light intensity, and pavement contamination levels. Specific steps (
Figure 1) were as follows: Surface dust was gently removed using a small fan and sterile brush; sterile cotton balls moistened with physiological saline were placed on sampling points for 2–3 min; cotton balls were then transferred into sterile sample bags, sealed, and labeled with sample number, collection time, and location. Sampling points were spaced 10 m apart, totaling five samples.
After sampling, cotton balls were placed in bottles containing 100 mL of mineral salt medium and cultured in a shaker at 30 °C for 3 days for primary enrichment. Subsequently, 1 mL of the culture broth was transferred into asphalt liquid medium and cultured under the same conditions for another 3 days; this enrichment step was repeated three times. After enrichment, the broth was diluted using a 10-fold serial dilution method [
10]. Aliquots of 100 μL from dilution gradients of 10
−5, 10
−6, and 10
−7 were spread onto sterilized asphalt solid medium (three replicates per dilution) and incubated at 30 °C for 48 h, with colony morphology recorded as shown in
Table 2. Based on
Table 2, colonies exhibiting vigorous growth and high density were selected. Single strains were obtained through repeated streaking and purification on LB solid medium. Finally, the strains were preserved using the glycerol stock method [
11] for subsequent identification and experimentation.
For subsequent performance testing, bacterial suspensions were prepared as shown in
Figure 2: First, bacterial pellets were obtained by centrifugation at 5000 rpm for 10 min at room temperature. Pellets were washed with sterile 0.9% physiological saline and centrifuged again for 10 min; this washing step was repeated twice to remove residual medium effects. Finally, 50 mL of sterile 0.9% physiological saline was added to the pellet and thoroughly mixed to ensure uniform cell dispersion, yielding the bacterial suspension [
6]. The bacterial suspension was subsequently inoculated onto asphalt samples to facilitate thorough contact between microorganisms and the binder, thereby enabling comparative assessment of asphalt performance before and after microbial activity.
2.1.3. Asphalt and Microbial Treatment Scheme
This study utilized Donghai 70# paving asphalt, produced by Sinopec Maoming Company (China), as the base asphalt material. Its basic physical properties are listed in
Table 3.
SBS-modified asphalt was prepared by incorporating 4% (by mass) SBS modifier into the base asphalt through high-temperature shearing and thermal blending processes (
Figure 3).
To simulate the asphalt film morphology in mixtures and enhance microbial contact efficiency, rolling thin film oven (RTFO) asphalt specimens were prepared according to SH/T 0736 [
13] by heating at 163 °C for 60 min. Compared to traditional casting methods, this approach ensured uniform film thickness, increased contact area between asphalt and microorganisms, and reduced component segregation risks during manual pouring. Subsequently, bacterial suspensions from
Section 2.1.2 were inoculated into sample bottles according to the groupings in
Table 4 to enable full microbial-asphalt interaction for performance assessment.
As shown in
Table 4, three sample types were established based on inoculation: (1) Blank groups (Base-null, SBS-null), without bacterial suspension inoculation, to exclude effects of RTFO heating on asphalt aging; (2) active bacterial inoculation groups (Base-5d, Base-10d, Base-15d; SBS-5d, SBS-10d, SBS-15d), inoculated with active bacterial suspension for 5, 10, and 15 days, respectively, to assess microbial effects on asphalt properties; and (3) sterilized control groups (Base Control-15d, SBS Control-15d), inoculated with bacterial suspension sterilized by autoclaving (121 °C, 103.4 kPa, 30 min), followed by UV sterilization [
14] (30 min) to exclude non-biological factor interference (e.g., solution components). To prevent contamination and cross-contamination, bottle mouths were sealed with colorless transparent plastic film (
Figure 4). After specific activity periods, asphalt samples were retrieved for conventional (penetration, softening point, ductility) and rheological performance testing across temperature ranges.
2.2. Test Methods
2.2.1. Molecular Biological Identification of Microorganisms
Total DNA was extracted from microbial samples using the E.Z.N.A.® Soil DNA Kit (Omega Bio-tek, Norcross, GA, USA) according to manufacturer protocols. The V1–V9 region of the bacterial 16S ribosomal RNA gene was amplified by polymerase chain reaction (PCR) using universal primers 27F (5’-AGRGTTYGATYMTGGCTCAG-3’) and 1492R (5’-RGYTACCTTGTTACGACTT-3’). The PCR mixture (20 μL) contained diluted DNA template, 4 μL of 5 × FastPfu Buffer, 2 μL of 2.5 mmol/L dNTPs, 0.8 μL each of forward and reverse primers (5 μmol/L), 0.4 μL of FastPfu Polymerase, and ddH2O to volume. PCR conditions were 95 °C for 5 min; 25 cycles of 95 °C for 30 s, 55 °C for 30 s, 72 °C for 45 s; final extension at 72 °C for 10 min; hold at 10 °C.
PCR products were separated by 2% agarose gel electrophoresis and purified using the AxyPrep DNA Gel Extraction Kit (Axygen Biosciences, Union City, CA, USA). Amplified products with correct band sizes were sequenced by Shanghai Biozeron Biotechnology Co., Ltd. (Shanghai, China). Sequences were spliced and submitted to the National Center for Biotechnology Information (NCBI) GenBank database for homology comparison. Model strain sequences with highest similarity were downloaded, and a phylogenetic tree was constructed using the maximum likelihood (ML) method in MEGA 11.0 (v11.0.13) software.
2.2.2. Conventional Properties Testing
Conventional properties (penetration, softening point, ductility) of base and SBS-modified asphalt after microbial activity were tested according to the Standard Test Methods of Bitumen and Bituminous Mixtures for Highway Engineering (JTG E20-2011) [
12]. Penetration tests were conducted at 25 °C with a 100 g load for 5 s. Softening point was determined by the ring-and-ball method. Ductility tests were conducted at 10 °C for base asphalt and 5 °C for SBS-modified asphalt, adhering to JTG E20-2011 standards for modified binders requiring lower test temperatures due to enhanced flexibility. All samples were derived from the film preparation and microbial activity system described in
Section 2.1.3 and tested according to
Table 4 groupings and activity periods (5, 10, 15 days). Blank and control groups were treated identically.
2.2.3. Rheological Performance Testing
To systematically evaluate the viscoelastic response of asphalt before and after microbial activity, all samples were tested using a dynamic shear rheometer (DSR; model: SMART-102E). Rheological properties were analyzed through temperature sweep (TS), multiple stress creep recovery (MSCR), linear amplitude sweep (LAS), and 4 mm DSR tests. Unless otherwise specified, tests were performed with 3 replicates. Films were prepared and grouped (
Table 4) as described in
Section 2.1.3, with linear viscoelastic (LVE) range confirmed before testing.
Temperature Sweep
According to ASTM D7175 [
15], temperature sweep tests were conducted using 25 mm parallel plates with a 1 mm gap. Strain was controlled at 10%, angular frequency at 10 rad/s, and temperature range 46–82 °C in 6 °C increments. The rutting factor (
G*/sin
δ) was used to evaluate high-temperature deformation resistance, with higher values indicating better stability.
Multiple Stress Creep Recovery
Per ASTM D7405 [
16], MSCR tests evaluated high-temperature performance at 64 °C using 25 mm parallel plates and a 1 mm gap. Continuous loading was applied at stress levels of 0.1 kPa and 3.2 kPa (10 cycles per stress). Each cycle comprised 1 s loading and 9 s recovery. Percent recovery (
R) and non-recoverable creep compliance (
Jnr) were used as evaluation indices, with stress sensitivity indices Rdiff and Jnr-diff calculated using Equations (1)–(4):
where
τ is the stress level (0.1 kPa, 3.2 kPa),
γc is the final creep strain of each cycle,
γr is the final creep strain of each recovery period, and
γ0 is the initial creep strain of each cycle.
Linear Amplitude Sweep
Per AASHTO TP 101 [
17], LAS tests were performed at 25 °C using 8 mm parallel plates with a 2 mm gap to evaluate intermediate-temperature fatigue resistance. Testing comprised two steps:
Step 1: Frequency sweep at 0.1% strain, 0.2–30 Hz. Storage modulus
G’(
ω) versus frequency
ω was fitted using Equation (5) to obtain slope
m and intercept
b, then material parameter
α was calculated via Equation (6):
where
G’(
ω) is the storage modulus, Pa;
ω is the frequency, rad/s; and
m and
b are fitting parameters.
Step 2: Amplitude sweep at fixed frequency (10 Hz), total loading time 310 s (3100 cycles), strain amplitude linearly increasing from 0.1% to 30%. The damage accumulation function
D(
t) (Equation (7)) quantified material damage evolution, and fatigue life
Nf was calculated via Equation (8):
where
D(
t) is the cumulative damage;
ID is the initial dynamic modulus at strain of 1.0%, MPa; |
G*| is the dynamic modulus, Pa;
δ is the phase angle,
t is the test time, s;
A35,
B are parameters;
γmax is the predicted maximum strain of pavement structure, %;
f is the loading frequency, which is 10 Hz; and
Nf is the fatigue life.
4 mm DSR Testing
Due to limited asphalt sample mass, 4 mm DSR methodology [
18,
19] was employed to assess low-temperature rheological properties. Frequency sweeps were conducted at −15 °C and −5 °C in strain-controlled mode (0.1% strain amplitude, 0.1–100 rad/s frequency range).
Based on time-temperature superposition, the storage modulus master curve
G’(
ω) was constructed using −15 °C as the reference temperature. This was converted to the relaxation modulus master curve
G(
t) using Equation (9).
G(
t) was fitted with a quadratic polynomial
y = ax2 + bx + c (a, b, c: fitting parameters). Relaxation modulus
G(60 s) and relaxation rate
mr(60 s) at 60 s were extracted as evaluation indices for low-temperature rheological performance [
20] via Equations (10) and (11):
3. Results and Discussion
3.1. Identification of Microorganisms
Through multi-gradient enrichment and screening, two strains exhibiting robust growth on asphalt medium were isolated from in-service pavement surfaces, designated Am and Bm. As shown in
Figure 5, colonies of Am and Bm appeared creamy white and pale yellow, respectively. Both displayed circular morphology with neat edges, moist smooth surfaces, and slight convexity (48 h cultivation at 30 °C, details in
Section 2.1.2).
A phylogenetic tree based on 16S rRNA gene sequences was constructed using the maximum likelihood (ML) method in MEGA 11.0 (
Figure 6). Homology analysis revealed that strain Am shared 98.84% similarity with the type strain
Pseudomonas putida NBRC 14164, exceeding the species delineation threshold of 98.7% [
21]. Combined with phylogenetic topology, Am was identified as
Pseudomonas putida. In contrast, strain Bm showed only 98.10% similarity with
Citrobacter freundii ATCC 8090, below the species threshold. Within the ML phylogenetic tree, Bm formed a distinct branch divergent from reported
Citrobacter species, with key node bootstrap values ≥ 70% (
Figure 6). Thus, Bm was identified as a putative novel species of the genus
Citrobacter (order
Enterobacterales), though its taxonomic status requires further validation through DNA-DNA hybridization (DDH) [
22] or average nucleotide identity (ANI) [
23] genomic analyses.
3.2. Conventional Properties Analysis
Table 5 summarizes changes in penetration, softening point, and ductility of base and SBS-modified asphalt after microbial activity periods of 5, 10, and 15 days. Overall, microbial action reduced penetration, increased softening point, and decreased ductility in both asphalt types, indicating asphalt hardening and reduced low-temperature ductility.
For base asphalt (
Table 5), penetration decreased from 66.3 (0.1 mm) at 0 d to 41.5 at 15 d (approximately 37.4% reduction); ductility (10 °C) decreased from 58 cm to 27 cm (approximately 53.4% reduction); softening point exhibited non-monotonic change: initial increase (5 d), subsequent decrease (10 d), and final increase (15 d). This staged fluctuation suggests that microbial consumption of light fractions initially induced "resin enrichment" hardening, elevating softening point. At mid-term, partial degradation of macromolecular structures and generation of low-molecular-weight products reduced softening point. With prolonged activity, structural rearrangement or further hardening restored softening point elevation, though specific mechanisms require further study. Control groups (0 d and 15 d sterilized) exhibited stable properties, confirming changes resulted from active microorganisms rather than sample preparation or storage.
SBS-modified asphalt showed similar trends to base asphalt but with significantly reduced magnitude and more monotonic progression: Penetration decreased from 53.6 (0.1 mm) to 45.2 (approximately 15.7% reduction); ductility (5 °C) decreased from 28.6 cm to 20.7 cm (approximately 27.6% reduction); softening point increased from 77.8 °C to 82.5 °C (approximately 6.0% increase). The gradual trend in SBS systems indicates the polymer network structure delayed microbial erosion of the matrix and performance deterioration.
3.3. Rheological Properties
3.3.1. Temperature Sweep Analysis
The rutting factor (
G*/sin
δ) determined by temperature sweep tests effectively characterizes asphalt’s high-temperature deformation resistance.
Figure 7 shows that base and SBS-modified asphalt exhibited significantly different
G*/sin
δ evolution patterns after microbial activity.
Temperature sweep results (
Figure 7) demonstrate that microbial action significantly impacts the
G*/sin
δ of asphalt and exhibits distinct material-dependent characteristics. Compared to the control group (Control-15d) subjected solely to sterilized suspension soaking, both base asphalt and SBS-modified asphalt after 15 days of microbial activity showed markedly reduced
G*/sin
δ across the entire temperature range (46–82 °C), with the reduction magnitude amplifying as temperature increased. Furthermore, extending the microbial activity duration from 5 to 15 days progressively intensified the detrimental effects of microbial action on the high-temperature performance of asphalt.
For base asphalt (
Figure 7a),
G*/sin
δ curves shifted upward after 5 d activity compared to controls (Base Control-15d), indicating slight improvement in high-temperature stability. This may result from preferential degradation of light fractions temporarily increasing resin and asphaltene proportions, causing apparent hardening. At 10 d,
G*/sin
δ curves shifted downward significantly. At 15 d,
G*/sin
δ partially recovered but remained lower than controls—reductions at 46, 52, 58, 64, 70, 76, and 82 °C were 42.8%, 44.5%, 45.7%, 46.2%, 45.9%, 45.3%, and 44.4%, respectively—demonstrating long-term microbial degradation of high-temperature performance. Potential mechanisms include microbial disruption of macromolecular components, requiring further investigation. In contrast, SBS-modified asphalt (
Figure 7b) exhibited monotonic
G*/sin
δ reduction from initial activity, with more pronounced degradation at higher temperatures. After 15 d, reductions versus control (SBS Control-15d) ranged from 46.7% (46 °C) to 62.0% (82 °C), where the 82 °C reduction was 1.33 times that at 46 °C. This indicates microbial degradation of SBS asphalt high-temperature stability is amplified in high-temperature regions.
Notably, temperature sweep results appear inconsistent with conventional indices (penetration decrease, softening point increase suggesting “harder” material), while
G*/sin
δ decreased. This discrepancy may arise because conventional metrics reflect static stiffness and thermal softening temperature, whereas
G*/sin
δ integrates dynamic shear stiffness and phase angle. Microbial alteration of colloidal balance (e.g., reduced light fractions, changed polar component ratios) may increase stiffness but decrease elastic fraction and elevate phase angle δ, thereby reducing
G*/sin
δ. This trend aligns with higher permanent deformation rates under high stress in MSCR tests (
Section 3.3.2), further confirming microbial degradation of high-temperature rutting resistance.
3.3.2. MSCR Tests Analysis
Figure 8 compares changes in strain recovery rate (
R) and non-recoverable creep compliance (
Jnr) for base and SBS-modified asphalt after different microbial activity periods. Higher
R values indicate superior elastic recovery capacity, while lower
Jnr values signify better deformation resistance [
24].
Figure 8 results demonstrate that microbial action generally compromises asphalt’s high-temperature performance, with this detrimental effect intensifying at elevated stress levels. Specifically, under low stress (0.1 kPa), after 15 days of microbial activity,
Jnr increased by approximately 29% for base asphalt and 16% for SBS-modified asphalt compared to sterilized controls, while
R decreased by approximately 17% and 9%, respectively. When stress increased to 3.2 kPa, these differences amplified substantially:
Jnr increased by approximately 56% with
R decreasing by approximately 28% for base asphalt; for SBS-modified asphalt,
Jnr increased by approximately 34% with
R decreasing by approximately 15%. Particularly in base asphalt, the
Jnr increase at 3.2 kPa approached twice that at 0.1 kPa, indicating more pronounced microbial-induced high-temperature deterioration under high stress. Notably, this stress-dependence aligns with the "amplified reduction at elevated temperatures" observed in temperature sweeps (
Section 3.3.1): under high-temperature/high-stress conditions, microbial-mediated colloidal relaxation and polymer network disruption accelerate fluidity enhancement, thereby promoting permanent deformation accumulation. While SBS-modified asphalt maintained moderate elastic recovery capacity (higher
R) under low stress, this advantage substantially diminished under high stress, indicating reduced load-bearing limits of the polymer network following prolonged microbial activity.
Analysis of R and Jnr variation trends at different activity periods reveals distinct behavioral patterns between asphalt types. For base asphalt, R decreased and Jnr increased from 5 d to 10 d, while R increased and Jnr decreased from 10 d to 15 d. This wave-like fluctuation may result from microbial degradation dynamics: initial consumption of light components reduces high-temperature performance, followed by partial recovery as microbial breakdown of heavy molecular components generates low-molecular-weight compounds that rebalance asphalt composition. In contrast, SBS-modified asphalt exhibits monotonic changes in R and Jnr throughout microbial activity. Under low stress (0.1 kPa), R decreased by approximately 18–19% while Jnr increased by approximately 36–67% from 5 d to 15 d. Under high stress (3.2 kPa), R decreased by approximately 21–29% and Jnr increased by approximately 42–70%. These results demonstrate that microbial-induced deterioration of high-temperature performance in SBS-modified asphalt intensifies with prolonged activity, particularly under high-stress conditions.
3.3.3. LAS Tests Analysis
LAS tests evaluated the impact of microbial action on intermediate-temperature fatigue resistance. Shear stress–strain curves for both asphalt types after different activity periods are shown in
Figure 9. Microbial activity altered yield strain and failure modes in a material-dependent manner. For base asphalt (
Figure 9a), the 5-day sample exhibited the lowest yield strain and rapid failure after peak stress, while 10-day and 15-day samples demonstrated progressive failure. In contrast, SBS-modified asphalt (
Figure 9b) showed abrupt failure at 5 days but maintained higher post-peak strain rates. At 10 and 15 days, progressive damage patterns emerged, indicating that the polymer network delays fatigue degradation in modified asphalt.
To quantify fatigue tolerance, the damage characteristic curves of base asphalt and SBS-modified asphalt after microbial activity over different time periods are presented in
Figure 10. The slope of these curves represents the rate of damage progression [
25]. The integrity parameter C indicates the extent of damage sustained by the asphalt under loading, while the damage parameter D quantifies cumulative microstructural failure [
26,
27,
28]. When C is equal to 1, the asphalt remains in an undamaged state; when C is equal to 0, it indicates complete failure [
29].
For base asphalt (
Figure 10a), C values increased overall with activity time. At D = 2000, the 15-day sample showed significantly elevated C, suggesting transient enhancement in strain tolerance. This may relate to microbial consumption of light fractions altering resin-asphaltene ratios, temporarily improving stiffness and crack resistance. However, this improvement was insufficient to offset overall fatigue life reduction. For SBS-modified asphalt (
Figure 10b), C values at 5 days were lower than same-period base asphalt but stabilized at 10 and 15 days. This indicates the polymer network inhibits further fatigue degradation and maintains stable fatigue resistance.
Figure 11 presents the fatigue life of base asphalt and SBS-modified asphalt at varying strain levels (2.5%, 5%, 7.5%, 10%) following microbial activity. As shown in
Figure 11a, the fatigue life of base asphalt exhibited a consistent "initial decrease, subsequent increase, and final reduction" pattern across all strain levels with prolonged microbial activity time. The early-stage decline may originate from microbial consumption of light components and initial structural weakening. The transient recovery at intermediate stages could be associated with elastic improvement resulting from resin-to-asphaltene ratio adjustments. However, long-term deterioration ultimately occurred due to colloidal structure disruption, revealing the complex mechanism of microbial effects on the fatigue performance of base asphalt. For SBS-modified asphalt (
Figure 11b), fatigue life decreased substantially at 5 d but partially recovered at 10 d and 15 d, particularly at higher strain levels. This indicates that the polymer network structure not only enhances resistance to microbial degradation but also delays crack propagation through stress redistribution after partial degradation, thereby mitigating the reduction in fatigue life [
23].
LAS results demonstrate that microbial action compromises the fatigue resistance of asphalt, with this deterioration exhibiting distinct time-dependent and material-specific characteristics. Within the microbial activity periods (5 d, 10 d, 15 d), base asphalt showed transient performance recovery at intermediate stages, while SBS-modified asphalt maintained more stable fatigue resistance under the protective effect of its polymer network.
3.3.4. 4 mm DSR Analysis
Low-temperature performance of asphalt samples after microbial activity was evaluated using 4 mm DSR methodology. Frequency sweeps at varying temperatures generated storage modulus master curves
G’(
ω) for both base and SBS-modified asphalt, as illustrated in
Figure 12 and
Figure 13. For base asphalt (
Figure 12), the
G’(
ω) curves exhibited minimal morphological differences across microbial activity periods (5 d, 10 d, 15 d). However, lower
G’(
ω) values at the low-frequency end compared to the control group (Base Control-15d) indicated reduced low-temperature stiffness and improved crack resistance. This improvement was limited in magnitude and showed no significant cumulative effect over time. In contrast, SBS-modified asphalt (
Figure 13) displayed pronounced fluctuations in
G’(
ω) with microbial activity. Relative to the control (SBS Control-15d),
G’(
ω) increased significantly in the high-frequency region after 5 d of activity but decreased markedly at 10 d and 15 d. This suggests initial deterioration in low-temperature stiffness (performance degradation), followed by progressive improvement with prolonged microbial action.
Using Equation (9), the storage modulus
G’(
ω) was converted to the relaxation modulus
G(
t), with results shown in
Figure 14. As demonstrated in
Figure 14a, the
G(
t) curves for base asphalt after microbial treatment were generally slightly lower than those of the control group (Base Control-15d), indicating a slight improvement in low-temperature performance due to microbial action. In marked contrast, for SBS-modified asphalt (
Figure 14b), compared with SBS Control-15d, the
G(
t) for SBS-5d was slightly elevated, while showing significant reduction at 10 d and 15 d. This demonstrates that with prolonged microbial activity, the low-temperature performance of SBS-modified asphalt transitions from short-term degradation to significant improvement and stabilization.
To quantitatively analyze the effect of microbial action on the low-temperature rheological behavior of asphalt, relaxation modulus
G(60 s) and relaxation rate
mr(60 s) at 60 s were calculated using Equations (10) and (11), respectively, with results presented in
Table 6. Lower relaxation modulus and higher absolute relaxation rate values indicate superior low-temperature crack resistance of asphalt [
30]. Given minimal variation in
mr(60 s), this study focuses on
G(60 s) results. As indicated in
Table 6, the
G(60 s) values of base asphalt after 5 d, 10 d, and 15 d of microbial activity were all lower than those of the control group (Base-Control-15d), though differences among the three time points were negligible. These results suggest that microbial action moderately improves the low-temperature performance of base asphalt, with limited magnitude and no significant variation over time—consistent with the trends shown in
Figure 14. For SBS-modified asphalt, the
G(60 s) value after 5 d of microbial action was higher than that of the control group, indicating a reduction in low-temperature performance. In contrast, after 10 d and 15 d of microbial activity,
G(60 s) decreased relative to the control, reaching the lowest value at 15 d, which corresponds to the most pronounced improvement in low-temperature performance. A potential explanation is that microbial activity may induce non-directional degradation or reorganization of the polymer network within SBS-modified asphalt, though further investigation is required to elucidate the precise mechanisms.
4. Conclusions
This study isolated two asphalt-degrading bacterial strains from in-service pavements. A thin-film inoculation system with staged microbial activity periods systematically evaluated their impact on conventional and multi-temperature rheological properties of base and SBS-modified asphalt. The key findings reveal distinct response patterns to microbial action:
(1) Following microbial activity, both base asphalt and SBS-modified asphalt exhibited reduced penetration, elevated softening point, and diminished ductility. Among these changes, the magnitude of variation in base asphalt was significantly greater than that in SBS-modified asphalt.
(2) Following microbial activity, both base asphalt and SBS-modified asphalt exhibited decreased G*/sinδ across the 46–82 °C temperature range, with more pronounced reductions observed in high-temperature regions. This indicates compromised rutting resistance in both materials after microbial action. Furthermore, the degradation of high-temperature performance induced by microorganisms manifested more significantly under high-stress conditions.
(3) LAS testing results demonstrate that microbial action generally reduces the fatigue resistance of asphalt. However, this deterioration exhibits significant time-dependency and material-specific characteristics: base asphalt shows an overall decrease in fatigue life with periodic fluctuations, while SBS-modified asphalt exhibits marked reduction at 5 d followed by recovery and stabilization between 10 and 15 d, indicating SBS modification mitigates microbial-induced impairment of asphalt fatigue performance.
(4) Following microbial activity, base asphalt exhibited limited improvement in low-temperature performance with no significant differences observed across activity periods. For SBS-modified asphalt, low-temperature performance deteriorated after 5 d of microbial action but demonstrated significant improvement and stabilization between 10 and 15 d, indicating potential implications of microbial activity for the polymer network structure.
This study provided insights into the evolution patterns of multi-temperature performance across asphalt types under microbial influence, offering fundamental data and theoretical support for material selection, durability design, and maintenance of pavement materials in microbial-prone environments. However, this research was limited to rheological indices for analysis and lacked direct evidence of chemical composition alterations or microstructural changes. Future work should investigate the mechanisms of asphalt degradation from the perspectives of specific genes, genetic encoding, and the asphalt-degrading enzymes produced by the target microorganisms. Furthermore, the investigation covered limited microbial strain types and activity durations without considering multi-environmental coupling effects. Future studies should incorporate multi-scale characterization integrating chemical, rheological, and morphological analyses, expand microbial strain varieties and activity periods, introduce coupled environmental testing (e.g., humidity-thermal, UV, salt spray, freeze–thaw cycles), and explore synergistic applications of antimicrobial strategies with polymer modification technologies.
Author Contributions
Conceptualization, X.L. (Xiang Liu); data curation, T.S. and X.L. (Xiang Liu); formal analysis, T.S.; funding acquisition, T.S., S.Z., X.L. (Xiang Liu) and J.J.; investigation, T.S.; methodology, X.L. (Xiang Liu); project administration, S.Z., X.L. (Xiang Liu), X.L. (Xiaolong Li), J.J. and Z.W., resources, X.L. (Xiang Liu), X.L. (Xiaolong Li) and J.J.; supervision, S.Z. and X.L. (Xiang Liu); validation; T.S.; writing—original draft preparation, T.S.; writing—review &editing, X.L. (Xiang Liu). All authors have read and agreed to the published version of the manuscript.
Funding
This research was funded by Yunnan Fundamental Research Projects (grant No. 202301AU070065), Yunnan Provincial Department of Transportation Technology Innovation and Demonstration Project (grant No. 2022-73), the Fundamental Research Funds for the Central Universities, CHD (grant No. 300102213514), the Fund of Yunnan Digital Technology Innovation Centre of Modern Integrated Transportation (grant No. 202405AK340003), Projects of Science and Technology Department of Yunnan Province, China (grant No. 202401AT070060), and the Postdoctoral Research And Development Project of Yunnan Transportation Planning and Design Institute Co., Ltd. (grant No. YJSJ-BSHYF-2022-01).
Institutional Review Board Statement
Not applicable.
Informed Consent Statement
Not applicable.
Data Availability Statement
The original contributions presented in this study are included in the article. Further inquiries can be directed to the corresponding author.
Conflicts of Interest
Author Shaopeng Zheng was employed by Broadvision Engineering Consultants. Xiang Liu was employed by Faculty of Transportation Engineering, Kunming University of Science and Technology. Xiaolong Li, Jingpeng Jia were employed by Yunnan Science & Technology Research Institute of Highway. Zhibo Wang was employed by Yunnan Communications Investment & Construction Group Co., LTD. The remaining authors declare that the research was conducted in the absence of any commercial or financial relationships that could be construed as a potential conflict of interest.
References
- Li, J. Asphalt pavement material dispersion and the role of microorganisms. Yunnan Commun. Sci. Technol. 1996, 12, 32–34. (In Chinese) [Google Scholar]
- Hao, P.; Wang, S.; Zhang, D. The Effect of the Microbial Activity on the Adhesion between Asphalt and Aggregate. Pet. Asph. 1998, 12, 43–46. (In Chinese) [Google Scholar]
- Burgess, S. Action of microorganisms on petroleum-asphalt fractions. Highw. Res. Board Bull. 1956, 27–48. [Google Scholar]
- Harris, J.O.; Worley, H.E.; McCaskili, G.A.; Baldwin, L.K. Preliminary studies of the effect of microorganisms on physical properties of asphalt. Trans. Kans. Acad. Sci. 1958, 61, 110–113. [Google Scholar] [CrossRef]
- Zhang, H.; Hu, Z.; Hou, S.; Xu, T. Effects of microbial degradation on morphology, chemical compositions and microstructures of bitumen. Constr. Build. Mater. 2020, 248, 118569. [Google Scholar] [CrossRef]
- Zhang, H.; Hu, Z.; Hou, S.; Xu, T. Aging behaviors of bitumen degraded by the microbial consortium on bituminous pavement. Constr. Build. Mater. 2020, 254, 119333. [Google Scholar] [CrossRef]
- Zhang, H.; Xia, W.; Hu, Z.; Xu, T. Inhibitory effects of developed composite anti-aging agent on microbial degradation of asphalt. Constr. Build. Mater. 2021, 292, 123399. [Google Scholar] [CrossRef]
- Traxler, R.W.; Proteau, P.R.; Traxler, R.N. Action of microorganisms on bituminous materials. I. Effect of bacteria on asphalt viscosity. Appl. Microbiol. 1965, 13, 838–841. [Google Scholar] [CrossRef]
- Phillips, U.A.; Traxler, R.W. Microbial degradation of asphalt. Appl. Microbiol. 1963, 11, 235–238. [Google Scholar] [CrossRef] [PubMed]
- Brenes-Alvarado, A.; Farias-da-Silva, F.F.; Soto-Montero, J.R.; Benine-Warlet, J.; Groppo, F.C.; Steiner-Oliveira, C. Reduction of microorganisms in carious dentin by photodynamic therapy mediated by potassium iodide added to methylene blue and red laser. Arch. Oral Biol. 2024, 164, 105978. [Google Scholar] [CrossRef] [PubMed]
- Mahapatra, S.; Kopf, S.H.; Halamka, T.; Merten, C.; Drost, D.A.; Minnaard, A.J. Total Synthesis of the Membrane Spanning Tetraether Lipid brGDGT Ia and Elucidation of Its Stereochemical Configuration. Chem. A Eur. J. 2025, 31, e202500702. [Google Scholar] [CrossRef]
- JTG E20-2011; Standard Test Methods of Bitumen and Bituminous Mixtures for Highway Engineering. Ministry of Transport: Beijing, China, 2011.
- SH/T 0736-2003; Standard Test Method for Effect of Heat and Air on a Moving Film of Asphalt (Rolling Thin-Film Oven Test). National Development and Reform Commission: Beijing, China, 2004.
- Li, Y.; Zhang, L.; He, Y.; Zhang, X.; Liu, X. Intelligent pulsed ultraviolet c radiation sterilization system: A cleaner solution of raw ready-to-eat aquatic products processing. J. Clean. Prod. 2023, 427, 139281. [Google Scholar] [CrossRef]
- ASTM D7175-23; Standard Test Method for Determining the Rheological Properties of Asphalt Binder Using a Dynamic Shear Rheometer. American Society for Testing and Materials: West Conshohocken, PA, USA, 2023.
- ASTM D7405-24; Standard Test Method for Multiple Stress Creep and Recovery (MSCR) of Asphalt Binder Using a Dynamic Shear Rheometer. American Society for Testing and Materials: West Conshohocken, PA, USA, 2024.
- AASHTO TP101-2012 (2018)1; Estimating Damage Tolerance of Asphalt Binders Using Linear Amplitude Sweep. American Association of State Highway and Transportation Officials: Washington, DC, USA, 2018.
- Sui, C.; Farrar, M.J.; Harnsberger, P.M.; Tuminello, W.H.; Turner, T.F. New Low-Temperature Performance-Grading Method Using 4-mm Parallel Plates on a Dynamic Shear Rheometer. Transp. Res. Rec. 2011, 2207, 43–48. [Google Scholar] [CrossRef]
- Sui, C.; Farrar, M.J.; Tuminello, W.H.; Turner, T.F. New Technique for Measuring Low-Temperature Properties of Asphalt Binders with Small Amounts of Material. Transp. Res. Rec. 2010, 2179, 23–28. [Google Scholar] [CrossRef]
- Farrar, M.J.; Sui, C.; Qin, Q. Determining the Rheological Properties of Asphalt Binder Using a Dynamic Shear Rheometer (DSR). 2015. Available online: https://nazhco.com/wp-content/uploads/2020/08/315dsr-.pdf (accessed on 15 June 2023).
- Stackebrandt, E. Taxonomic parameters revisited: Tarnished gold standards. Microb. Today 2006, 33, 152. [Google Scholar]
- Kang, C.-H.; Nam, Y.-D.; Chung, W.-H.; Quan, Z.-X.; Park, Y.-H.; Park, S.-J.; Desmone, R.; Wan, X.-F.; Rhee, S.-K. Relationship between genome similarity and DNA-DNA hybridization among closely related bacteria. J. Microbiol. Biotechnol. 2007, 17, 945–951. [Google Scholar]
- Cao, Y.; Feng, H.; Cheng, K.; Liu, B.; Du, H.; Xie, J.; Xin, D.; Yao, S. Identification of Clostridium sporogenes by average nucleotide identity based on whole genome sequencing. Food Ferment. Ind. 2022, 48, 44–49. [Google Scholar]
- Li, Y.; Huang, W.; Zhao, S.; Yan, Z.; He, F.; Hu, C.; Shen, S. Influence of rejuvenator components on rheological properties of recycled bitumen in the full temperature range. Constr. Build. Mater. 2024, 414, 134789. [Google Scholar] [CrossRef]
- Lu, J.; Ma, T.; Chen, C.; Shi, S.; Zhang, Y. The feasibility of using several soybean oil-based derivatives for asphalt binder modification: A preliminary study. Constr. Build. Mater. 2023, 391, 131735. [Google Scholar] [CrossRef]
- Xu, G.; Wang, H.; Zhu, H. Rheological properties and anti-aging performance of asphalt binder modified with wood lignin. Constr. Build. Mater. 2017, 151, 801–808. [Google Scholar] [CrossRef]
- Shi, K.; Ma, F.; Liu, J.; Fu, Z.; Song, R.; Yuan, D.; Ogbon, A.W. Evolution of SBS-modified asphalt performance under aging and rejuvenation cycle conditions. Constr. Build. Mater. 2024, 416, 135156. [Google Scholar] [CrossRef]
- Chen, C.; Podolsky, J.H.; Williams, R.C.; Cochran, E.W. Laboratory investigation of using acrylated epoxidized soybean oil (AESO) for asphalt modification. Constr. Build. Mater. 2018, 187, 267–279. [Google Scholar] [CrossRef]
- Li, Q.; Zeng, X.; Wang, J.; Luo, S.; Meng, Y.; Gao, L.; Wang, X. Aging performance of high viscosity modified asphalt under complex heat-light-water coupled conditions. Constr. Build. Mater. 2022, 325, 126314. [Google Scholar]
- Wang, C. Low Temperature Rheological Road Performance of Road Asphalt. In Rheology of Paving Asphalt; Communications Press: Beijing, China, 2019. [Google Scholar]
Figure 1.
Microbial screening process.
Figure 1.
Microbial screening process.
Figure 2.
Preparation process of bacterial suspension.
Figure 2.
Preparation process of bacterial suspension.
Figure 3.
Preparation of SBS-modified asphalt.
Figure 3.
Preparation of SBS-modified asphalt.
Figure 4.
Sterile sealing of sample bottles using transparent plastic film.
Figure 4.
Sterile sealing of sample bottles using transparent plastic film.
Figure 5.
Colony Morphology of Strains Am and Bm.
Figure 5.
Colony Morphology of Strains Am and Bm.
Figure 6.
Maximum Likelihood Phylogenetic Tree based on 16S rRNA Gene Sequences of Strains Am and Bm and Related Taxa.
Figure 6.
Maximum Likelihood Phylogenetic Tree based on 16S rRNA Gene Sequences of Strains Am and Bm and Related Taxa.
Figure 7.
Temperature sweep results for (a) base asphalt and (b) SBS-modified asphalt after microbial activity.
Figure 7.
Temperature sweep results for (a) base asphalt and (b) SBS-modified asphalt after microbial activity.
Figure 8.
The R and Jnr of the base and SBS-modified asphalt after microbial activity.
Figure 8.
The R and Jnr of the base and SBS-modified asphalt after microbial activity.
Figure 9.
Stress–strain curves from LAS tests for (a) base asphalt and (b) SBS-modified asphalt after microbial activity.
Figure 9.
Stress–strain curves from LAS tests for (a) base asphalt and (b) SBS-modified asphalt after microbial activity.
Figure 10.
C–D curves from LAS tests for (a) base asphalt and (b) SBS-modified asphalt after microbial activity.
Figure 10.
C–D curves from LAS tests for (a) base asphalt and (b) SBS-modified asphalt after microbial activity.
Figure 11.
Fatigue life of (a) base asphalt and (b) SBS-modified asphalt after microbial activity.
Figure 11.
Fatigue life of (a) base asphalt and (b) SBS-modified asphalt after microbial activity.
Figure 12.
G’(ω) master curves of base asphalt after microbial activity.
Figure 12.
G’(ω) master curves of base asphalt after microbial activity.
Figure 13.
G’(ω) master curves of SBS-modified asphalt after microbial activity.
Figure 13.
G’(ω) master curves of SBS-modified asphalt after microbial activity.
Figure 14.
Main curve of low temperature relaxation modulus G(t) for (a) base asphalt and (b) SBS-modified asphalt after microbial activity.
Figure 14.
Main curve of low temperature relaxation modulus G(t) for (a) base asphalt and (b) SBS-modified asphalt after microbial activity.
Table 1.
Composition of mineral salt medium, asphalt liquid medium, asphalt solid medium, and Luria–Bertani (LB) solid medium.
Table 1.
Composition of mineral salt medium, asphalt liquid medium, asphalt solid medium, and Luria–Bertani (LB) solid medium.
| Types of Culture Medium | Components |
|---|
| Mineral salt medium | NH4NO3 1.0 g, CaCl2 0.1 g, K2HPO4 0.5 g, FeCl3 0.02 g, KH2PO4 0.5 g, MnSO4·7H2O 0.5 g, NaCl 1.0 g, yeast extract 0.05 g, distilled water 1000 mL |
| Asphalt liquid medium | Mineral salt medium, asphalt 1.0 g |
| Asphalt solid medium | LB solid medium, asphalt 1.0 g |
| Luria–Bertani (LB) solid medium | yeast extract 0.05 g, tryptone 10.0 g, NaCl 10.0 g, agar 20.0 g, distilled water 1000 mL |
Table 2.
Microbial colonies cultured in asphalt solid medium for 48 h.
Table 3.
The basic physical properties of the base asphalt.
Table 3.
The basic physical properties of the base asphalt.
| Physical Property | Test Result | Quality Requirement | Test Standard [12] |
|---|
| Penetration, 25 °C (0.1 mm) | 66.3 | 60–80 | T 0604 |
| Softening Point (°C) | 47.0 | ≥46.0 | T 0606 |
| Ductility, 15 °C (cm) | >100 | ≥100 | T 0605 |
| Ductility, 10 °C (cm) | 58 | ≥25 | T 0605 |
| Kinematic Viscosity, 60 °C (Pa·s) | 230 | ≥180 | T 0620 |
| Wax Content (%) | 1.98 | ≤2.2 | T 0615 |
| Solubility (%) | 99.98 | ≥99.5 | T 0607 |
| Flash Point (°C) | 295 | ≥260 | T 0611 |
| Density (15 °C) | 1.035 | Recorded | T 0603 |
| Thin Film Oven Test (163 °C, 5 h) |
| Mass Change (%) | −0.182 | ±0.8 | T 0609 |
| Penetration Ratio (%) | 62.1 | ≥61.0 | T 0604 |
| Ductility, 10 °C (cm) | 6 | ≥6 | T 0605 |
Table 4.
Grouping of asphalt samples and microbial inoculation conditions.
Table 4.
Grouping of asphalt samples and microbial inoculation conditions.
| Group | Asphalt Type | Inoculation Type | Duration
(days) | Temperature
(°C) |
|---|
| Base-null | Base asphalt | None | 0 | 25 |
| Base-5d | Active bacterial suspension | 5 |
| Base-10d | Active bacterial suspension | 10 |
| Base-15d | Active bacterial suspension | 15 |
| Base Control-15d | Sterilized bacterial suspension | 15 |
| SBS-null | SBS-modified asphalt | None | 0 |
| SBS-5d | Active bacterial suspension | 5 |
| SBS-10d | Active bacterial suspension | 10 |
| SBS-15d | Active bacterial suspension | 15 |
| SBS Control-15d | Sterilized bacterial suspension | 15 |
Table 5.
Conventional properties of base asphalt and SBS-modified asphalt.
Table 5.
Conventional properties of base asphalt and SBS-modified asphalt.
| Group | Asphalt Type | Soaking Solution Action Time
(days) | Penetration, 25 °C
(0.1 mm) | Softening Point
(°C) | Ductility
(cm) |
|---|
| 10 °C | 5 °C |
|---|
| Base-null | Base asphalt | 0 | 66.3 | 47.0 | 58 | |
| Base-5d | 5 | 58.7 | 56.8 | 42 |
| Base-10d | 10 | 49.2 | 52.3 | 37 |
| Base-15d | 15 | 41.5 | 61.4 | 27 |
| Base Control-15d | 15 | 66.1 | 47.2 | 57.5 |
| SBS-null | SBS-modified asphalt | 0 | 53.6 | 77.8 | | 28.6 |
| SBS-5d | 5 | 50.1 | 79.5 | 25 |
| SBS-10d | 10 | 47.8 | 81.2 | 23 |
| SBS-15d | 15 | 45.2 | 82.5 | 20.7 |
| SBS Control-15d | 15 | 53.3 | 77.9 | 28.8 |
Table 6.
Fitting results of relaxation modulus master curve equation.
Table 6.
Fitting results of relaxation modulus master curve equation.
| Group | Fitting Master Curve Equation | G(60 s) | mr(60 s) |
|---|
| Base-null | y = −0.05196x2 − 0.33461x + 7.97894 | 384.23 | −0.52 |
| Base-5d | y = −0.03674x2 − 0.27117x + 8.27414 | 709.27 | −0.4 |
| Base-10d | y = −0.03923x2 − 0.27973x + 8.24113 | 659.07 | −0.42 |
| Base-15d | y = −0.04011x2 − 0.29154x + 8.31197 | 700.9 | −0.43 |
| Base Control-15d | y = −0.03567x2 − 0.25633x + 8.36502 | 829.03 | −0.38 |
| SBS-null | y = −0.04976x2 − 0.32251x + 8.44795 | 748.25 | −0.5 |
| SBS-5d | y = −0.04116x2 − 0.30056x + 8.10339 | 518.26 | −0.45 |
| SBS-10d | y = −0.02115x2 − 0.22369x + 6.06325 | 30.23 | −0.3 |
| SBS-15d | y = −0.000915x2 − 0.29307x + 5.79518 | 16.54 | −0.33 |
| SBS Control-15d | y = −0.03253x2 − 0.25467x + 7.96857 | 500.57 | −0.37 |
| Disclaimer/Publisher’s Note: The statements, opinions and data contained in all publications are solely those of the individual author(s) and contributor(s) and not of MDPI and/or the editor(s). MDPI and/or the editor(s) disclaim responsibility for any injury to people or property resulting from any ideas, methods, instructions or products referred to in the content. |
© 2025 by the authors. Licensee MDPI, Basel, Switzerland. This article is an open access article distributed under the terms and conditions of the Creative Commons Attribution (CC BY) license (https://creativecommons.org/licenses/by/4.0/).